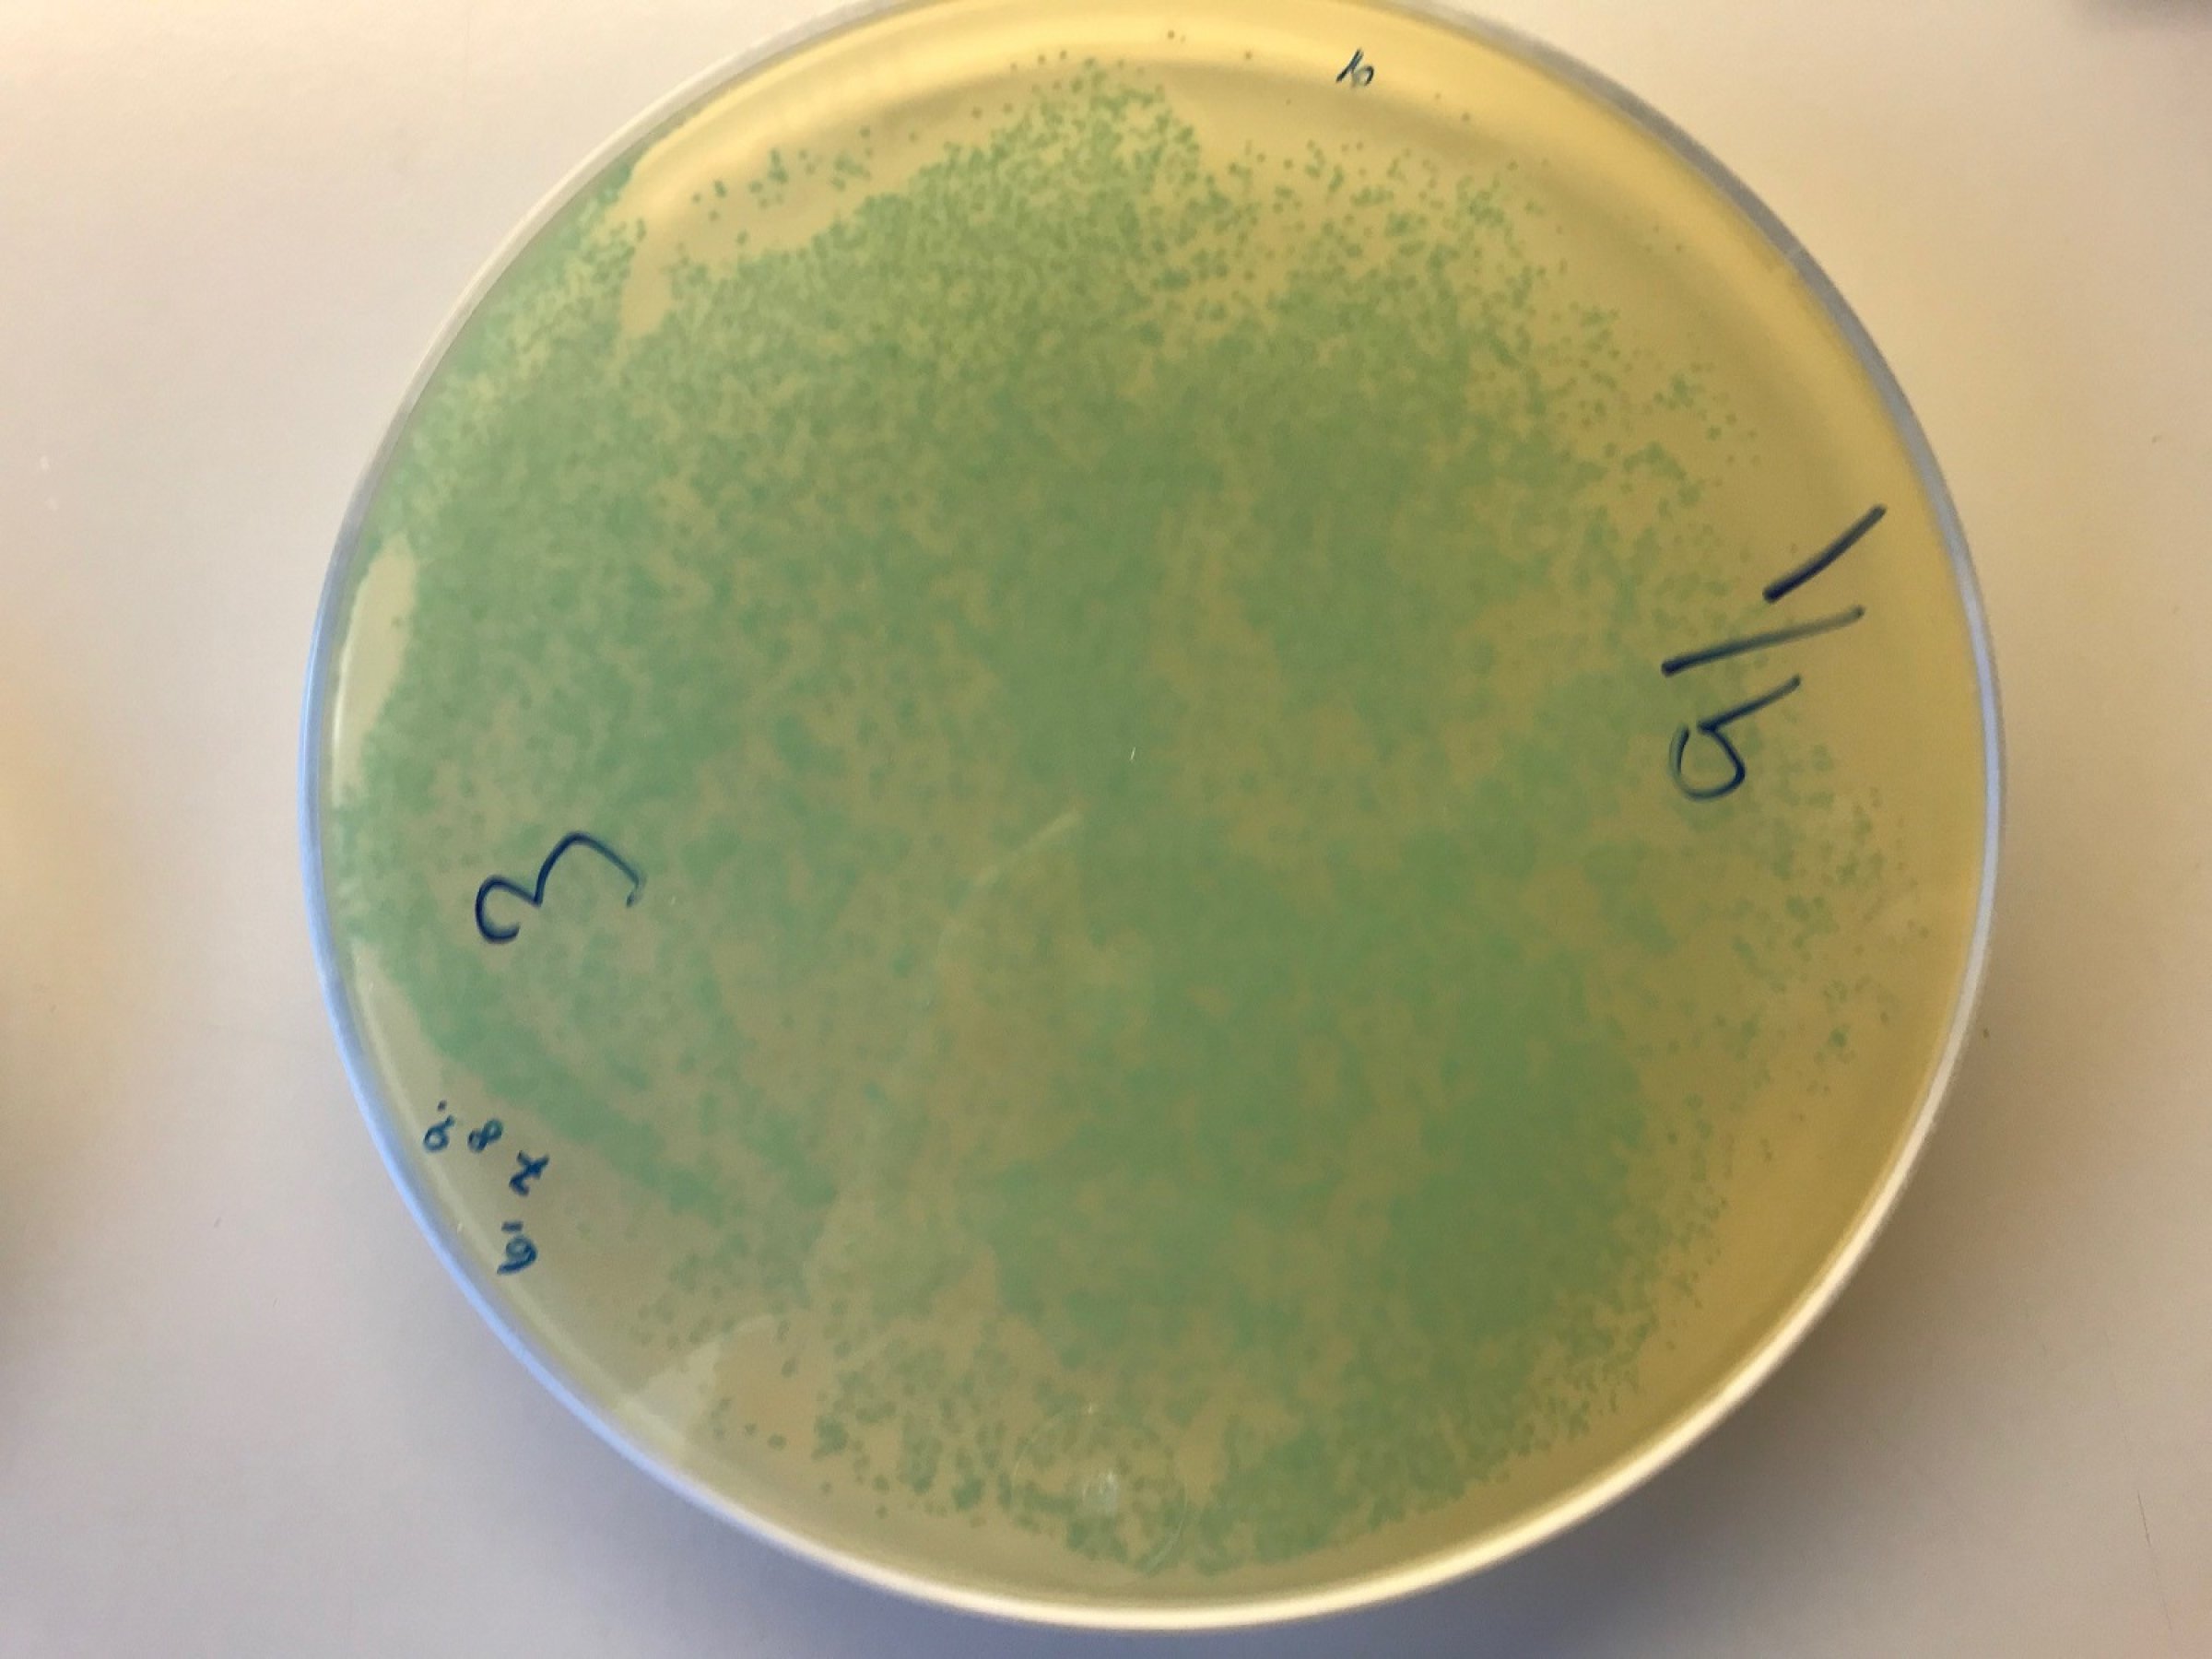
Listeriose er ein sjeldan, men alvorleg sjukdom som hovudsakleg råkar gravide, eldre med svekka helsetilstand og andre personar med nedsett immunforsvar. Foto: Veterinærinstituttet

Listeria påvist i rakfisk
Veterinærinstituttet har påvist listeria i prøven av rakfisk som blei sendt over frå Mattilsynet i går. Veterinærinstituttet har varsla Mattilsynet og Folkehelseinstituttet om funnet av bakterien Listeria monocytogenes i samband med auken i sjukdomstilfeller av listeriose for tida
- Den undersøkte prøven syner ei massiv forurensing av listeriabakteriar. Derom herskar det ikkje tvil, fortel Taran Skjerdal som forskar på listeria og trygg mat ved Veterinærinstituttet. Prøven er tatt ut av ei uopna pakke med rakfisk frå ein norsk produsent. Veterinærinstituttet har sendt isolat frå prøva vidare til Folkehelseinstituttet som vil samanlikne desse med isolat frå pasientprøvar.
Bistår vidare
- Utfrå forsking her på Veterinærinstituttet veit vi at listeria kan oppformeire seg raskt i sjølve produksjonsprosessen av rakfisk. Om fisken først er forureinsa, er det derfor ikkje nok med god kjøling og god kjøkkenhygiene for å unngå sjukdom. I motsetning til andre matvarer vil det alt vil vere store mengder listeria i fisken dersom produktet er forureinsa frå produksjonen.
Veterinærinstituttet vil bistå Mattilsynet og Folkehelseinstituttet med diagnostikk og rådgjeving i det vidare arbeidet for å oppklare listeriosetilfella.
Veterinærinstituttet vil bistå Mattilsynet og Folkehelseinstituttet med diagnostikk og rådgjeving i det vidare arbeidet gjennom for å oppklare listeriatilfella.
Om sjukdomen
Listeriose er ein sjeldan, men alvorleg sjukdom som hovudsakleg råkar gravide, eldre med svekka helsetilstand og andre personar med nedsett immunforsvar.
Listeria smitter ofte gjennom enkelte typar mat. Dette gjeld særleg matvarer som rakfisk som ein kan lagre lenge kjøleg, og som så blir spist utan vidare varmebehandling. Desse matprodukta er gjerne populære som julemat og det er difor ikkje overraskande at nye sjukdomstilfelle blir kjende no. Inkubasjonstida er sterkt varierande frå 24 timar til opp til tre månader.
For meir informasjon om tilfella ein no undersøker, syner vi til oppdaterte meldingar frå Folkehelseinstituttet og Mattilsynet og til meldinga lagt ut på www.vetinst.no i går. Lenke og lenke
Veterinærinstituttet har rolla som nasjonalt referanselaboratorium for listeria frå fôr, dyr og mat. Sjå vårt faktaark om listeria for meir informasjon om sjukdomen
Veterinærinstituttet har utarbeida ei handbok om listeria for produksjonsverksemder
For meir informasjon om tilfella
- Les melding frå Folkehelseinstituttet
- Les melding frå Mattilsynet
- Les melding om tilbaketrekking av rakfisk på matportalen.no
